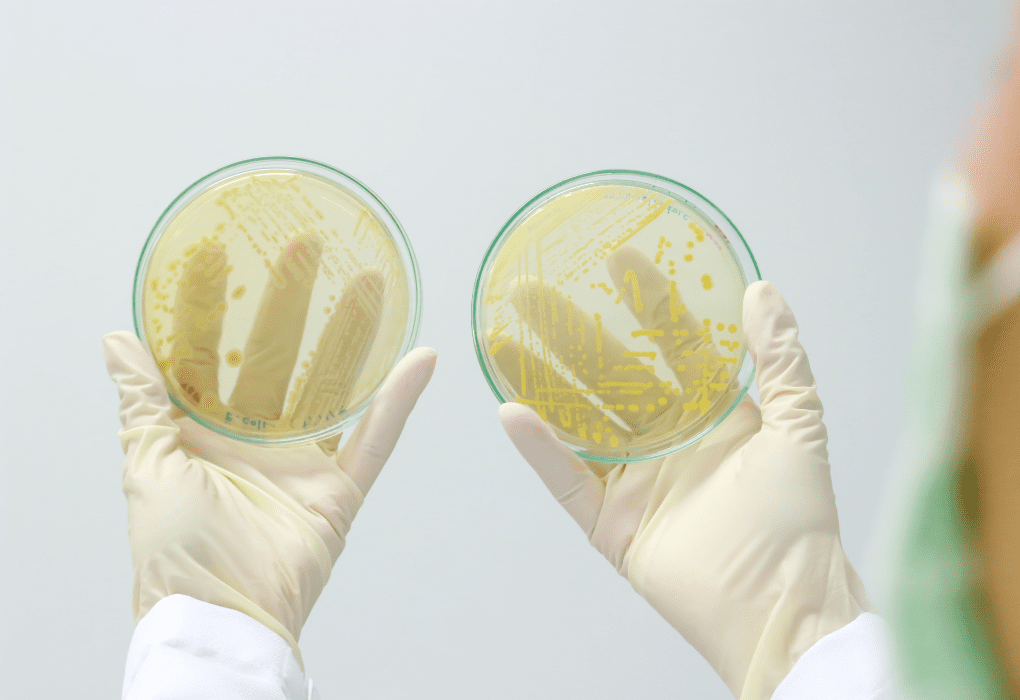

一起遠離肚子吃壞的困擾,一張圖秒懂9個注意事項,遠離食安

一起遠離肚子吃壞的困擾,學習專家教您的防範細菌原則和注意事項!
在家煮飯讓人感到溫暖又親切,近期食安問題與梅雨季節即將到來,氣溫和濕度的上升讓細菌性食品中毒的風險也隨之提高。
博登希望讓您有舒適機能的廚房外,也希望您和家人每天都能享受美味又健康的食物!更加健康安全

- 1、如何讓家人健康都能得到保障?
-
2、日本專家提出了3大原則、9個注意事項,抵禦細菌原則,從這三項開始
食物中毒是指細菌和病毒黏附在食品上或食品中含有微生物和化學物等有害物質,食用後引起嘔吐、腹瀉、腹痛或發燒等症狀。以金黃葡萄球菌的腸毒素為例,要加熱至100°C持續2小時才會被破壞。而在食物製作或保存不當下,細菌繁殖或其生產出的毒素過多,食入人體便會造成食物中毒,博登與您分享,遵循專家提供的建議,保護自己的健康。
日本專家提出預防食物中毒,這是一門學問,遵守以下3大原則,9個注意事項:

1、日常採購:
- ●要注意食材的外觀和保存期限:
- 選擇新鮮度較高的食材,如果可能的話,選擇有外膜包裝的蔬果。不要在採購後去其他地方,建議使用保冷袋和保冷劑,預防高溫下食物腐壞。

-
●食材保存:
生鮮食品回家後,要放入冷凍或冷藏室,魚類和肉類要做好分隔包裝,冷凍時建議以一次取用的份量區隔,方便解凍時只取一次烹調需要的量。

-
2、料理方面:
-
●不讓細菌附著在食物表面:
徹底洗手、生熟食材完全分開。 在碰觸肉、魚類、雞蛋等食材前,務必要徹底洗手。使用過的菜刀和砧板,也要用熱水清洗乾淨,再使用洗潔精或小蘇打粉定期消毒殺菌。如果能區分成3類個別使用更好,分別處理生鮮、蔬菜水果和熟食。

-
●快速冷凍:
以免細菌滋生將食材快速冷凍是避免細菌滋生的好方法,因為大多數細菌在10度以下的環境會減緩繁殖速度,零下15度時則會停止活動。生鮮的肉類、魚類等在購買後應盡快放入冰箱冷藏,以避免細菌的增加。不過,還是要注意盡快食用完畢。

-
●烹調殺菌:
確保食品安全 烹調是殺菌的最佳方法,幾乎所有細菌都可藉由加熱達到殺菌效果。尤其是生鮮肉類等食材,在烹調前應該確實加熱(全熟或至少中心部位達到75度以上),以確保食品安全。
-
●料理前置作業:
冷凍食材需要解凍時,建議使用微波爐的解凍功能,解凍之後盡快加以烹調。

-
3、食物保存方面:
-
●用餐:
使用清潔的餐具盛裝食物,煮好的食材要盡快食用,上桌用餐前一定要徹底洗手。
-
●快吃快冰:
吃飽後「手摸盤子溫溫的」即可冷藏,溫度急速下降以減少細菌滋生,別等到睡前才冰。 -
覆熱食物:該餐吃完,避免反覆加熱。
學習這些原則和注意事項,能有效防範細菌,
博登希望讓您有舒適機能的廚房外,也希望您和家人每天都能享受美味又健康的食物!更加健康安全
歡迎分享給您親戚好友~
___________________________
生活的美好其實是透過不同的感官組合而成,
溫馨風格的空間規劃運用,
不但大器、沉穩、舒適,最重要的是充滿幸福的溫度。
高雄廚具博登室內裝修設計公司一步步的把客戶心中的夢想廚房一點點劃出來....
高雄Takara廚具-博登室內裝修設計公司期待完成客戶夢想中的廚房。
高雄廚具博登是日本廚具推薦 ,高雄廚具博登會根據客戶的具體情況,提供廚具選擇和廚具設計推薦 ,協助您在打造夢想日式廚具的路上,對於廚具品牌有方向、有想法的規劃不再茫然,一步一步勾勒出廚房的樣子,20年來,高雄廚具博登已成功協助超過2000位以上客戶,讓他們的廚房煥然一新,使用廚房時倍感愉悅。

Takara standard日本琺瑯廚具博登の好宅設計 左營門市
☛高雄系統櫃官網
☛Takara廚具線上諮詢或預約
☛YouTubeTakara 琺瑯廚具
☛Google評論
☛地址│高雄市左營區自由四路181號
☛電話│07-346-0677 | 0988118788 | 0956812976
☛免費諮詢專線│0800-678-158
好文推薦-->眼不見為淨!高雄系統櫃找博登,將阿嬤的雜物通通收納!
